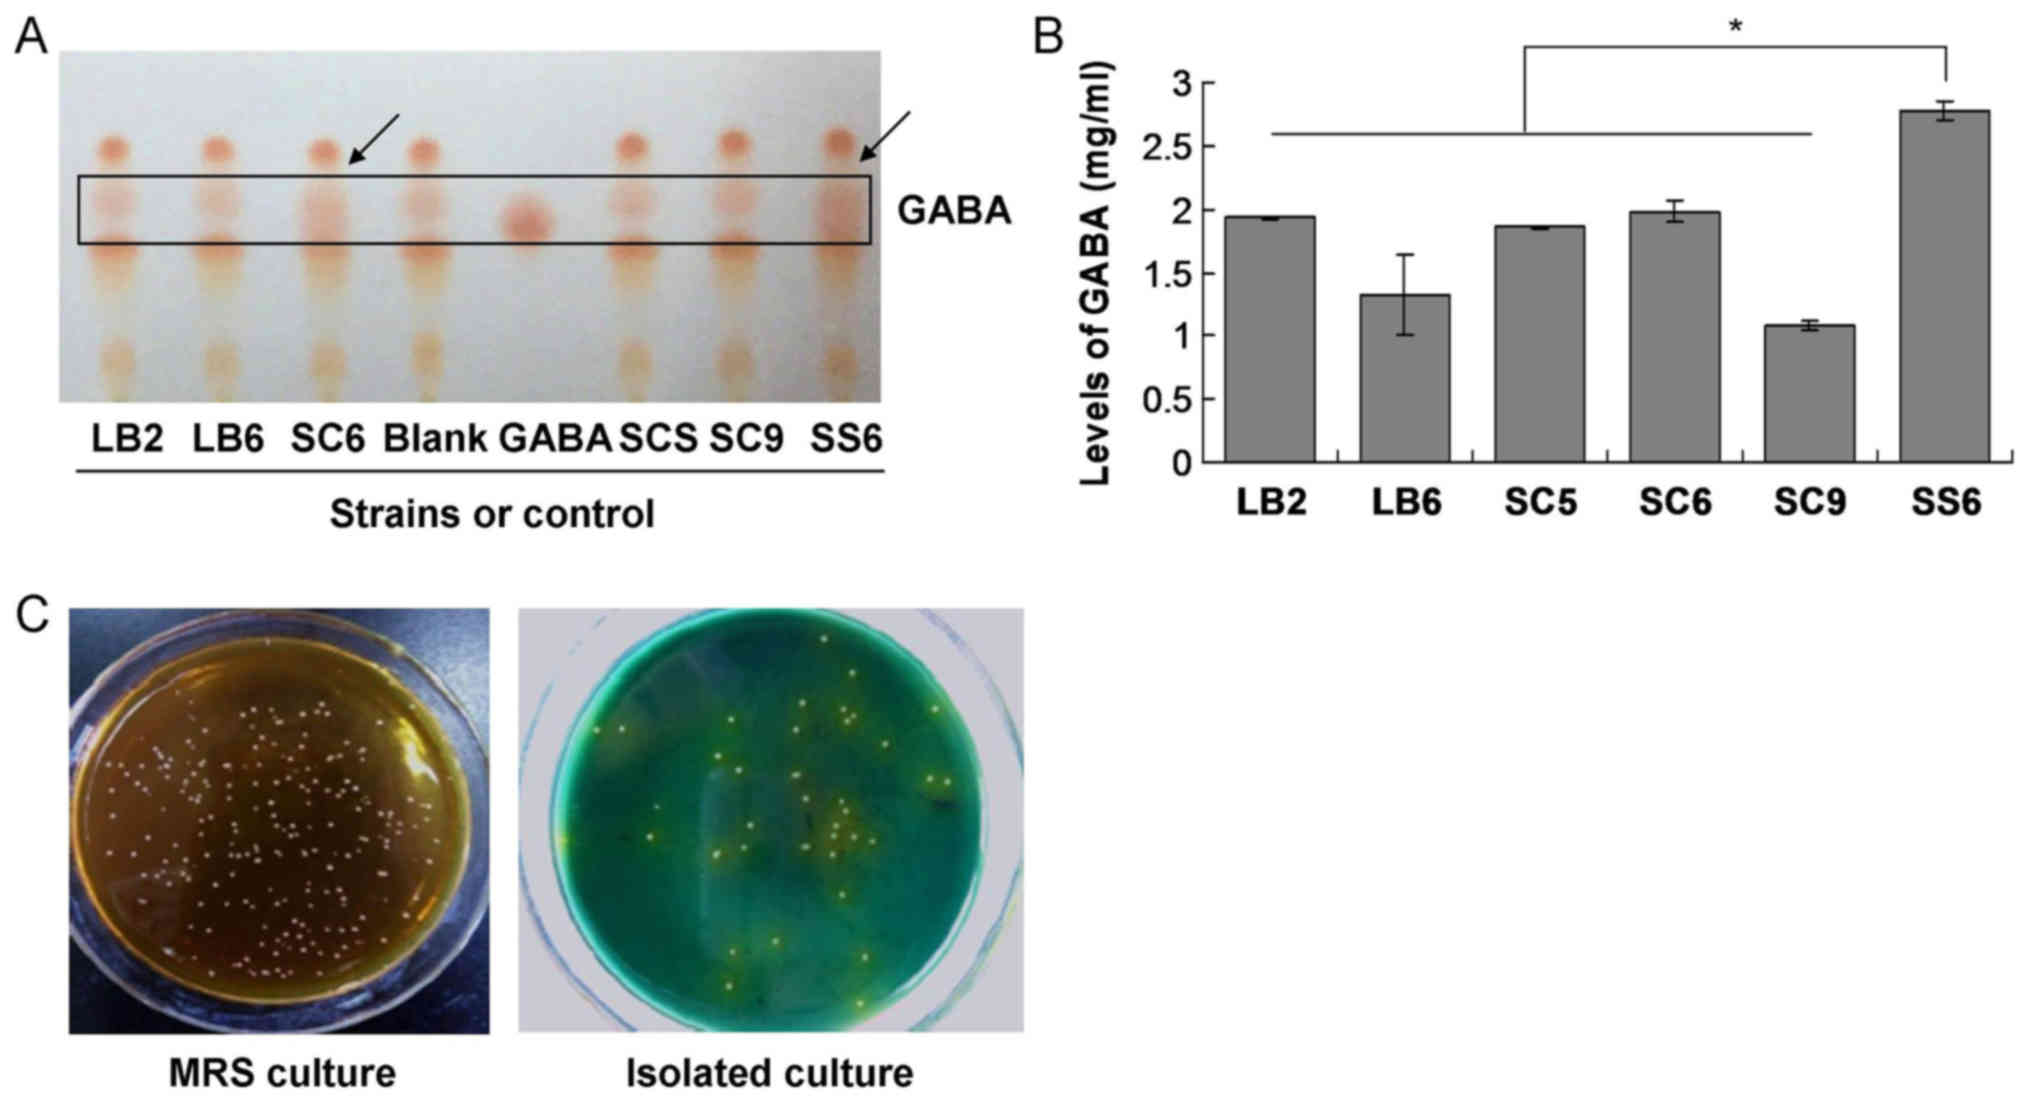

Introduction
γ-aminobutyric acid (GABA) is a non-protein amino
acid that is synthesized by glutamic acid decarboxylase (GAD)
(1,2). GABA has critical roles in the body,
e.g., as an important inhibitory neurotransmitter in sympathetic
nervous system, and supplementation of GABA has anti-diabetic and
anti-hypertensive effects in humans (3). Furthermore, GABA suppresses anxiety and
pain, controls the lipid levels and inhibits cancer cell
proliferation and growth (4,5). Following the clarification of the
physiological roles of GABA, it was developed as a novel functional
supplement and applied extensively in the pharmaceutical and food
industry.
Natural GABA mainly occurs in the vegetables and
fruit; however, only at low concentrations. Previous studies have
reported that GABA is usually produced by numerous types of
micro-organism, including yeasts, fungi and lactic acid bacteria
(LAB) (5–7). Among these micro-organisms, LAB
constitute the normal and resident flora in the gastrointestinal
tract of humans and animals, which are also considered to be safe
organisms by the food industry (8).
LAB is utilized to improve the texture, and enhance the sensory
profile and nutritional value of food or associated products
(9). Of note, the GABA produced by
LAB always exhibits higher biological activities compared with that
in food products and its synthetic process is considered to be safe
(8,9). Therefore, the technology of GABA
production by LAB has great potential for implementation in the
health product and pharmaceutical industry, and is worthy of
investigation.
In China, mulberry leaves have been used for
>5,000 years (10), and are also
being developed by the pharmaceutical industry. Of note, the
extracts of mulberry leaves possess multiple biopharmaceutical
activities, including anti-bacterial, anti-diabetic,
anti-atherogenic, anticancer, anti-inflammatory and anti-oxidant
effects, and have a therapeutic effect in cardiovascular and
hypolipidemic diseases (11). GABA
is an important active component of mulberry leaf extracts, from
which it was isolated in a previous study (12). However, the enrichment of GABA in
mulberry leaves is a critical problem that requires to be resolved
for the production of GABA and its medical application.
In order to enhance the yield of GABA isolated from
mulberry leaves for its further exploration as a health product,
the present study aimed to obtain GABA-enriched mulberry leaf
powders by using a strain of high GABA-yielding Lactobacillus
pentosus SS6 isolated from fermented mulberry fruits.
Materials and methods
Regents and materials
GABA was purchased from Sigma-Aldrich (Merck KGaA,
Darmstadt, Germany). The nutrient agars including de Man Rogosa and
Sharpe (MRS), tryptone extract glucose (TYG) and lactobacillus
isolation medium) were purchased from Guangdong Huankai Microbial
Sci. Tech. Co. Ltd. (Guangzhou, China). Peptone cat. No. LP0017T),
tryptone (cat. no. CM0595B), yeast extract (cat. no. LP0021B) and
beef extract (cat. no. CM0015B) were purchased from Beijing BioDee
Biotech. Co. Ltd. (Beijing, China). Massif blue G-250, glutamate,
sodium glutamate, K2HPO4, mercaptoethanol,
absolute ethyl alcohol, formaldehyde, methanol, acetone,
hydrochloric were purchased from Sigma-Aldrich (Merck KGaA). The
mulberry leaves were provided by Serigen Group (Guangzhou, China).
The mulberry leaves were turned into mulberry leaf powder by New
Toldhow Pharmaceutical Co. Ltd. (Jiangxi, China). The fresh
mulberries were purchased from Guangdong BSYCY Co. Ltd. (Guangzhou,
China).
Preparation of culture medium
The isolation of LAB and preparation of culture
medium were performed according to the protocol of a previous study
(13), following sterilization via
autoclave for 25 min and adjustment of the pH to 6.5 (13). The tryptone yeast extract glucose
(TYG) fermentation medium was prepared according to a previous
study (14), with the modifications
of addition of 2% L-Glu (1 mg/ml), adjustment of the pH to 6.5 and
sterilization for 25 min. The LAB medium was composed of skimmed
milk (12 g) and CaCO3 (0.2 g); sterilization was
performed for 25 min and the pH was adjusted to 6.5.
Isolation, culture and screening of
LAB
Isolation of LAB from the fermented mulberries (5 g)
was performed as previously described (15). The LAB was cultured according to a
previous study (16). In brief, the
isolated LAB was cultured in TYG culture medium at 37°C for 48 h.
The LAB screening was performed according to the study by Wu and
Shah (17) with the following
modifications: Supernatant fermentation liquid (1 µl) was added to
the thin-layer chromatography silica gel plate (cat. No. SG-004;
Qingdao Kangyexin Medical Silica Gel Desiccant Co., Ltd., Qingdao,
China). n-butyl alcohol: Glacial acetic acid: Water (4:1:3) was
considered as the developing agent. The 0.4% ninhydrin
(Sigma-Aldrich; Merck KGaA) was assigned as the chromogenic agent.
The isolated LAB was cultured in the TYG culture medium and
screened by using a ninhydrin colorimetry method [0.4% ninhydrin;
Sigma-Aldrich (Merck KGaA)] (16).
In brief, TYG with added GABA (1 mg/ml) was used as a positive
control and TYG without any reagents was used as a negative
control.
Carbon source and nitrogen source
treatment
The isolated LAB were added to the mulberry leaf
powder (100 g) culture (water content, 60%) at a proportion of 5%.
Glucose, saccharose or xylose was used as the carbon source, which
was individually added at concentrations of 0, 5, 10 or 15%. In
another experiment, peptone was used as the nitrogen source, which
was added at concentrations of 0, 2, 4, 6 or 8%. Subsequent to the
abovementioned additions, the mulberry leaf powder mixtures were
fermented via shaking for 36 h at 35°C using a 500 ml flask (Mode,
4100–0500; Pierce; Thermo Fisher Scientific, Inc., Waltham, MA,
USA).
K2HPO4
treatment
The isolated LAB was added to the mulberry leaf
powder culture (with a water content of 60%) at a final LAB
concentration of 5%. For the K2HPO4
treatment, K2HPO4 was added at concentrations
of 0, 0.4, 0.8, 1.2, 1.6, 3, 4 or 6%, followed by fermentation for
36 h at 35°C.
L-sodium glutamate treatment
To the LAB/mulberry leaf powder culture as specified
above, L-sodium glutamate was added at a concentration of 0, 0.5,
1, 1.5 or 3%, followed by fermentation as stated above.
Effects of water content, fermentation
time, LAB inoculated amount and temperature on the GABA
content
Various experimental conditions were examined in
order to determine those leading to the highest yield of GABA. The
water content was set at 30, 40, 50, 60 or 70%. The time of
fermentation was 0, 12, 24, 36 or 48 h. The amount of inoculated
LAB was 0, 1, 3, 5, 7 or 9%. The temperature was set at 25, 30, 35
or 43°C. In the preliminary experiments, the aforementioned varied
LAB content, water content and temperature were utilized. However,
the pre-experiment results revealed that the time point of 36 h and
an LAB content of 35 and 5% were the optimal treatments for the
current study. Therefore, the mulberry leaf powders were fermented
for 36 h at 35°C for each type of treatment.
Measurement of GABA content
The GABA content was evaluated by using the Merck
Purospher STAR RP-18e high-performance liquid chromatography system
(Merck KGaA) equipped with a reverse-phase column with 5 µm
external diameter, 4.6 mm internal diameter and 250 mm length
(Mode, Luna C18; Phenomenex, Inc., Torrance, CA, USA). The
processes for the GABA content measurement were according to those
of a previous study (18). The GABA
content was determined by comparing the peak area with that of the
associated GABA standard. Furthermore, mycelium biomass was
assessed using the colony-counting method (colony formation unit
counting) as previously described (19).
Statistical analysis
All of the data were analyzed by using SPSS software
22.0 (IBM Corp., Armonk, NY, USA). The quantitative data were
expressed as the mean ± standard deviation. Student's t-test was
used for analysis of differences between two groups. Analysis of
variance and Tukey's post-hoc test were used for comparing
measurement data between multiple groups. All of the data were
obtained from at least six independent measurements or experiments.
P<0.05 was considered to indicate a statistically significant
difference.
Results
Screening of the GABA-producing
LAB
In the present study, 6 strains among a total of 37
LAB strains were selected for producing GABA using thin layer
chromatography, as they exhibited GABA production at the same gel
position. The preliminary results indicated that the supernatants
of the fermentation culture of the SC6 and SS6 strains exhibited
higher levels of GABA than that of the others (Fig. 1A). However, compared with the SC6
strain, the SS6 stain exhibited higher levels of GABA (Fig. 1). Therefore, the SS6 strain was
employed to evaluate the production of GABA in the subsequent
experiments.
The SS6 strain produces the highest
GABA content in the fermentation broth
In order to evaluate the production of GABA induced
by the LAB strains, the LB2, LB6, SC5, SC6, SC9 and SS6
Lactobacillus pentosus strains were cultured. The results
indicated that the yield of GABA in the culture with the SS6 strain
was significantly higher than that in the cultures of the other
strains (P<0.05; Fig. 1B). The
SS6 LAB was also uniquely prepared using MRS and isolation culture
(Fig. 1C), and was employed in the
subsequent experiments.
Fermentation and enrichment of
mulberry leaf powder by LAB enhances the yield of GABA
As presented in Table
I, after the fermentation of mulberry leaf powder by the SS6
strain, the culture contained significantly higher levels of GABA
compared with those in the unfermented mulberry leaf powder mixture
(P<0.05). Furthermore, the pH value of the mulberry leaf powder
culture after fermentation was lower compared with that of the
unfermented mulberry leaf powder mixture. Furthermore, the amounts
of reduced sugar and total sugar in the fermented mulberry leaf
powder were significantly lower compared with those in the
unfermented mulberry leaf powder (P<0.05).
 | Table I.Physiocochemical indexes of
fermentation product. |
Table I.
Physiocochemical indexes of
fermentation product.
| Parameter | Mulberry leaf
powder mixture prior to fermentation | Fermented and
enriched mulberry leaf powder |
|---|
| GABA (mg/g) | 10.7±0.04 |
54.96±0.02a |
| pH | 6.256±0.01 | 5.9±0.06 |
| Acidity (%) | 1.35±0.07 |
4.77±0.11b |
| Reduced sugar
(mg/g) | 0.66±0.01 |
0.23±0.01b |
| Total sugar
(mg/g) | 54.95±0.06 |
32.86±0.04a |
| Flavone (mg/g) | 14.93±0.01 | 15.85±0.01 |
| Protein (mg/g) | 6.76±0.03 | 6.72±0.03 |
| Coarse fiber
(mg/g) | 219.1±0.31 | 205.4±0.17 |
| Mycelium biomass
[log(cfu/g)] | – |
3.95×109 |
Addition of 10% saccharose as the
optimal carbon source causes the greatest enhancement of GABA
production
The production of GABA and mycelium biomass was
evaluated in the cultures treated with glucose, saccharose or
xylose at different concentrations as carbon sources. The results
indicated that addition of saccharose, particularly at 5 and 10%,
resulted in a higher production of GABA compared with that achieved
with glucose and xylose treatment (P<0.05; Fig. 2A). The mycelium biomass in the
saccharose group (particularly the 10% group) was also
significantly higher compared with that in the glucose and xylose
groups (P<0.05; Fig. 2B).
Therefore, saccharose at 10% was determined to be the optimal
carbon source.
Addition of 6% peptone as a nitrogen
source enhances GABA production
The results indicated that the GABA production in
the 6% peptone group was significantly higher compared with that in
the groups treated with other concentrations of peptone (P<0.05;
Fig. 3A). However, the mycelium
biomass was highest in the 4% peptone-treated group, which suggests
that the GABA production is not consistent with the mycelium
biomass.
Addition of 1.6%
K2HPO4 enhances the production of GABA
The results indicated that the GABA production in
the 1.6% K2HPO4 treatment group was
significantly higher compared with that in the other
K2HPO4 treatment groups (P<0.05; Fig. 3B). However, the mycelium biomass in
the 0.8% K2HPO4 treatment group was higher
than that in the other groups (P<0.05; Fig. 3B).
Addition of 1% L-sodium glutamate
enhances the production of GABA
L-sodium glutamate was added to the mulberry leaf
powder culture in the experiments. The results indicated that
L-sodium glutamate at the concentration of 1% had the greatest
capacity to enhance the production of GABA compared with the other
concentrations (P<0.05; Fig. 3C).
However, the highest mycelium biomass was obtained with L-sodium
glutamate at 0.5% (Fig. 3C).
Water content and treatment time
affect GABA production
The results indicated that a water content of 60%
led to the highest GABA production and mycelium biomass compared to
the other concentrations (P<0.05; Fig. 4A). Furthermore, the GABA production
and mycelium biomass were highest if the incubation time the
mulberry leaf powder culture was 36 h (Fig. 4B).
The amount of LAB and the culture
temperature affect GABA production
According to the weight/volume ratio, 7% LAB amounts
used for inoculation achieved a significantly higher GABA
production compared with the other amounts assessed (P<0.05;
Fig. 4C). Furthermore, among all
incubation temperatures, the highest levels of GABA production and
mycelium biomass were achieved at 35°C (Fig. 4D).
Discussion
LAB have been reported to produce a series of
metabolites, including bacteriocins (20), vitamins (21), conjugated linoleic acid (22) and exopolysaccharides (23), all of which are always considered as
the basis of probiotic function. A potential metabolite produced by
the lactobacilli in the intestinal tract is GABA, which is linked
to the desirable effects on the host (24). Previous studies have indicated that
GABA has roles in maintaining homoeostasis and in the
brain-gut-microbiome axis (25,26). The
present study aimed to isolate a high GABA-yielding LAB strain from
mulberries and explore the optimal conditions for obtaining GABA
from a fermentation/enrichment culture of mulberry leaf powder with
LAB and various additives.
In the present study, the isolated SS6 strain
achieved the highest yield of GABA, and was therefore used in the
subsequent experiments. In order to determine the production of
GABA induced by the different LAB strains, the LB2, LB6, SC5, SC6,
SC9 and SS6 strains were used in fermentation/enrichment culture
with mulberry leaf powder. Comparison of the different strains
indicated that use of the SS6 strain achieved the highest yield of
GABA, which was therefore considered to be the best candidate for
the improvement for the GABA content and production. The SS6 strain
was used in the subsequent experiments for exploring the ideal
conditions for the mulberry leaf powder fermentation culture.
Apart from the production of GABA through chemical
synthesis in the laboratory, it may also be produced by
fermentation of biomaterials containing GABA, e.g., mulberry
leaves, in the presence of LAB. Of note, the production of GABA is
affected by different culture and fermentation conditions, which
require optimization. In the present study, the effects of the
addition of a carbon source, a nitrogen source,
K2HPO4 and L-sodium glutamate, as well as
variation of the water content, treatment time, amount of
inoculated LAB and the incubation temperature, on the production of
GABA were investigated, all of which were previously indicated to
affect the yield of GABA (27,28). The
results of the present study demonstrated that 10% saccharose, 6%
peptone, 1.6% K2HPO4 and 1% L-sodium
glutamate achieved the highest GABA production and/or mycelium
biomass compared with those at the other concentrations. These
results were comparable to those of previous studies, which
reported that the production of GABA is affected by LAB and also by
other micro-organisms (yeast) (29,30).
An important characteristic of probiotic bacteria is
that they have beneficial effects in the host. In the present
study, LAB produced GABA, which has potential health benefits and a
promising application in the pharmaceutical and food industry.
Although the present study provided numerous useful
results, it also had a few limitations. First, the present study
has not addressed whether the production of GABA by the original
strains is consistent with that by the strains after undergoing
multiple passages. Second, the current study only changed one
variable at a time, with all others remaining constant. The
combination of constant variables however, does not guarantee that
the highest yield is produced. For example, the addition of
K2HPO4 may alter the pH, which may then
effect other components. In further study, the different factors
that may affect GABA production will be considered.
In conclusion, the present study isolated the SS6
LAB strain from fermented mulberries. The strain was cultured with
mulberry leaf powder for producing GABA. In summary, 10%
saccharose, 6% peptone, 1.6% K2HPO4, 1%
L-sodium glutamate, as well as the appropriate water content and
temperature significantly improved and enhanced GABA production and
the mycelium biomass. In future study, combined reactions
(involving all the aforementioned factors) in which all conditions
are applied at the same time will be assessed. The present study
provided a basis for the production of GABA by the pharmaceutical
and food industry.
Acknowledgements
Not applicable.
Funding
The present study was supported by the Scientific
Research Project of Public Welfare Industry (Agriculture) of the
Ministry of Agriculture (grant no. 201403064) and the Guangdong
Science and Technology Project (grant no. 2017A020208044).
Availability of data and materials
All data generated or analyzed during this study are
included in this published article.
Authors' contributions
YZ, FC and MH performed the experiments. SW
performed the experiments and wrote the manuscript. FC designed the
study and wrote the manuscript. JL assisted in the study design.
All authors read and approved the final manuscript.
Ethical approval and consent to
participate
Not applicable.
Patient consent for publication
Not applicable.
Competing interests
Authors declare no competing financial or commercial
interests regarding this study.
References
|
1
|
Yu T, Jiang Z, Liu L and Fan Z: Decrease
of gamma-aminobutyric acid and zinc ions in the islet periportal
circulation stimulates glucagon secretion during hypoglycemia. Exp
Ther Med. 15:2507–2511. 2018.PubMed/NCBI
|
|
2
|
Kondoh T, Mallick HN and Torii K:
Activation of the gut-brain axis by dietary glutamate and
physiologic significance in energy homeostasis. Am J Clin Nutr. 90
(Suppl):832S–837S. 2009. View Article : Google Scholar : PubMed/NCBI
|
|
3
|
Wong CG, Bottiglieri T and Snead OC III:
GABA, gamma-hydroxybutyric acid, and neurological disease. Ann
Neurol. 54 (Suppl 6):S3–S12. 2003. View Article : Google Scholar : PubMed/NCBI
|
|
4
|
Miura D, Ito Y, Mizukuchi A, Kise M, Aoto
H and Yagasaki K: Hypocholesterolemic action of pre-germinated
brown rice in hepatoma-bearing rats. Life Sci. 79:259–264. 2006.
View Article : Google Scholar : PubMed/NCBI
|
|
5
|
Park KB and Oh SH: Production of yogurt
with enhanced levels of gamma-aminobutyric acid and valuable
nutrients using lactic acid bacteria and germinated soybean
extract. Bioresour Technol. 98:1675–1679. 2007. View Article : Google Scholar : PubMed/NCBI
|
|
6
|
Kim JY, Lee MY, Ji GE, Lee YS and Hwang
KT: Production of gamma-aminobutyric acid in black raspberry juice
during fermentation by Lactobacillus brevis GABA100. Int J
Food Microbiol. 130:12–16. 2009. View Article : Google Scholar : PubMed/NCBI
|
|
7
|
Chuang CY, Shi YC, You HP, Lo YH and Pan
TM: Antidepressant effect of GABA-rich monascus-fermented product
on forced swimming rat model. J Agric Food Chem. 59:3027–3034.
2011. View Article : Google Scholar : PubMed/NCBI
|
|
8
|
Barthelmebs L, Calas-Blanchard C,
Istamboulie G, Marty JL and Noguer T: Biosensors as analytical
tools in food fermentation industry. Adv Exp Med Biol. 698:293–307.
2010. View Article : Google Scholar : PubMed/NCBI
|
|
9
|
Lucke FK: Utilization of microbes to
process and preserve meat. Meat Sci. 56:105–115. 2000. View Article : Google Scholar : PubMed/NCBI
|
|
10
|
Wang D, Dong Z, Zhang Y, Guo K, Guo P,
Zhao P and Xia Q: Proteomics provides insight into the interaction
between mulberry and silkworm. J Proteome Res. 16:2472–2480. 2017.
View Article : Google Scholar : PubMed/NCBI
|
|
11
|
Gryn-Rynko A, Bazylak G and
Olszewska-Slonina D: New potential phytotherapeutics obtained from
white mulberry (Morus alba L.) leaves. Biomed Pharmacother.
84:628–636. 2016. View Article : Google Scholar : PubMed/NCBI
|
|
12
|
Chen H, He X, Liu Y, Li J, He Q, Zhang C,
Wei B, Zhang Y and Wang J: Extraction, purification and
anti-fatigue activity of gamma-aminobutyric acid from mulberry
(Morus alba L.) leaves. Sci Rep. 6:189332016. View Article : Google Scholar : PubMed/NCBI
|
|
13
|
Süle J, Kõrösi T, Hucker A and Varga L:
Evaluation of culture media for selective enumeration of
bifidobacteria and lactic acid bacteria. Braz J Microbiol.
45:1023–1030. 2014. View Article : Google Scholar : PubMed/NCBI
|
|
14
|
Zhao Z, Wei L, Li CY, Wang Z, Hu YW, Liu
CC and Ma F: Study on optimization of proportion between fermented
liquid and traditional cultural medium of bioflocculant production
and its flocculant performance considering the aerobic fermentation
of rice straw as substrate. Pak J Pharm Sci 27 (6 Suppl).
S2119–S2123. 2014.
|
|
15
|
Lee HJ, Lee H, Choi YI and Lee JJ: Effect
of lactic acid bacteria-fermented mulberry leaf extract on the
improvement of intestinal function in rats. Korean J Food Sci Anim
Resour. 37:561–570. 2017. View Article : Google Scholar : PubMed/NCBI
|
|
16
|
Tongpim S, Meidong R, Poudel P, Yoshino S,
Okugawa Y, Tashiro Y, Taniguchi M and Sakai K: Isolation of
thermophilic L-lactic acid producing bacteria showing
homo-fermentative manner under high aeration condition. J Biosci
Bioeng. 117:318–324. 2014. View Article : Google Scholar : PubMed/NCBI
|
|
17
|
Wu Q and Shah NP: Gas release-based
prescreening combined with reversed-phase HPLC quantitation for
efficient selection of high-gamma-aminobutyric acid
(GABA)-producing lactic acid bacteria. J Dairy Sci. 98:790–797.
2015. View Article : Google Scholar : PubMed/NCBI
|
|
18
|
Tajabadi N, Ebrahimpour A, Baradaran A,
Rahim RA, Mahyudin NA, Manap MY, Bakar FA and Saari N: Optimization
of gamma-aminobutyric acid production by Lactobacillus
plantarum Taj-Apis362 from honeybees. Molecules. 20:6654–6669.
2015. View Article : Google Scholar : PubMed/NCBI
|
|
19
|
Marino A, Bellinghieri V, Nostro A, Miceli
N, Tariano MF, Guvenc A and Bisignano G: In vitro effect of branch
extracts of Juniperus species from Turkey on staphylococcus aureus
biofilm. FEMS Immunol Med Microbiol. 59:470–476. 2010. View Article : Google Scholar : PubMed/NCBI
|
|
20
|
Barrett E, Ross RP, Fitzgerald GF and
Stanton C: Rapid screening method for analyzing the conjugated
linoleic acid production capabilities of bacterial cultures. Appl
Environ Microbiol. 73:2333–2337. 2007. View Article : Google Scholar : PubMed/NCBI
|
|
21
|
Crittenden RG, Martinez NR and Playne MJ:
Synthesis and utilisation of folate by yoghurt starter cultures and
probiotic bacteria. Int J Food Microbiol. 80:217–222. 2003.
View Article : Google Scholar : PubMed/NCBI
|
|
22
|
Rosberg-Cody E, Stanton C, O'Mahony L,
Wall R, Shanahan F, Quigley EM, Fitzgerald GF and Ross RP:
Recombinant lactobacilli expressing linoleic acid isomerase can
modulate the fatty acid composition of host adipose tissue in mice.
Microbiology. 157:609–615. 2011. View Article : Google Scholar : PubMed/NCBI
|
|
23
|
Sreekumar O and Hosono A: The
antimutagenic properties of a polysaccharide produced by
Bifidobacterium longum and its cultured milk against some
heterocyclic amines. Can J Microbiol. 44:1029–1036. 1998.
View Article : Google Scholar : PubMed/NCBI
|
|
24
|
Barrett E, Ross RP, O'Toole PW, Fitzgerald
GF and Stanton C: γ-Aminobutyric acid production by culturable
bacteria from the human intestine. J Appl Microbiol. 113:411–417.
2012. View Article : Google Scholar : PubMed/NCBI
|
|
25
|
Cryan JF and O'Mahony SM: The
microbiome-gut-brain axis: From bowel to behavior.
Neurogastroenterol Motil. 23:187–192. 2011. View Article : Google Scholar : PubMed/NCBI
|
|
26
|
McKay DM and Bienenstock J: The
interaction between mast cells and nerves in the gastrointestinal
tract. Immunol Today. 15:533–538. 1994. View Article : Google Scholar : PubMed/NCBI
|
|
27
|
Zhao A, Hu X, Pan L and Wang X: Isolation
and characterization of a gamma-aminobutyric acid producing strain
Lactobacillus buchneri WPZ001 that could efficiently utilize
xylose and corncob hydrolysate. Appl Microbiol Biotechnol.
99:3191–3200. 2015. View Article : Google Scholar : PubMed/NCBI
|
|
28
|
Brasca M, Hogenboom JA, Morandi S, Rosi V,
D'Incecco P, Silvetti T and Pellegrino L: Proteolytic activity and
production of γ-aminobutyric acid by streptococcus thermophilus
cultivated in microfiltered pasteurized milk. J Agric Food Chem.
64:8604–8614. 2016. View Article : Google Scholar : PubMed/NCBI
|
|
29
|
Tong JC, Mackay IR, Chin J, Law RH, Fayad
K and Rowley MJ: Enzymatic characterization of a recombinant
isoform hybrid of glutamic acid decarboxylase (rGAD67/65) expressed
in yeast. J Biotechnol. 97:183–190. 2002. View Article : Google Scholar : PubMed/NCBI
|
|
30
|
Binh TT, Ju WT, Jung WJ and Park RD:
Optimization of gamma-amino butyric acid production in a newly
isolated Lactobacillus brevis. Biotechnol Lett. 36:93–98.
2014. View Article : Google Scholar : PubMed/NCBI
|